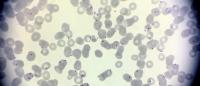

New Drugs Show Promise Against Malaria Parasite
In Brief
New, synthetic compounds that are potent killers of the malaria parasite are even more powerful when combined with current antimalarial drugs and are difficult for parasites to evade, according to a new study from researchers at Columbia and Stanford universities and an international team of collaborators.
The researchers tested the compounds in laboratory cultures of Plasmodium falciparum, the species that causes most malarial deaths.
“The compounds’ potency also extends to parasites that are resistant to current first-line artemisinin-based therapies, and that makes them particularly good candidates for combination therapies to treat multidrug-resistant malaria,” says David Fidock, PhD, the C.S. Hamish Young Professor of Immunology at Columbia University Vagelos College of Physicians and Surgeons and a senior author of the study.
Why It’s Important
Resistance to current antimalarial agents is spreading across Asia. New antimalarial drugs are needed, especially if resistance emerges in Africa, where the majority of the world’s 435,000 annual deaths from malaria occur.
Though many other antimalarial candidates are effective at killing malaria parasites, the parasites can easily develop resistance to those compounds.
Background
Malaria parasites reproduce rapidly and are highly dependent on their proteasome for survival. (The proteasome is a structure in the cell that breaks down unnecessary and toxic proteins and recycles the components.)
Although proteasome inhibitors are potent killers of the parasite, most compounds tested so far also impair the mammalian proteasome, preventing their use as antimalarials in people.
What’s New
The study tested two new compounds—called peptide vinyl sulfones—synthesized in the laboratory of co-author Matthew Bogyo, PhD, at Stanford University. The compounds inhibit the proteasome of the malaria parasite but have little effect on the human proteasome at low concentrations.
The researchers found that very low doses of both compounds killed malaria parasites and artemisinin-resistant strains equally well. Both inhibitors were even more toxic when combined with one of five different antimalarial drugs.
Parasites could only develop low-grade resistance to the compounds, requiring very large parasite numbers. This finding is in contrast to most other classes of preclinical candidates that prove to be much more mutable.
In addition, mutations that conferred resistance to one inhibitor frequently sensitized the parasites to the other inhibitor.
Next Steps
Efforts are ongoing to improve the toxicity of the inhibitors, increase the amount of drug that reaches the parasites when delivered orally, and identify the most suitable partner drugs for new combination therapies.
References
David Fidock is a professor in the Department of Microbiology & Immunology and in the Department of Medicine at Columbia University Vagelos College of Physicians and Surgeons.
The research was published June 6, 2019, in PLOS Pathogens in an article titled “Covalent Plasmodium falciparum-selective proteasome inhibitors exhibit a low propensity for generating resistance in vitroand synergize with multiple antimalarial agents.”
Additional authors: Barbara H. Stokes (Columbia University Irving Medical Center); Euna Yoo (Stanford University School of Medicine); James M. Murithi (CUIMC); Madeline R. Luth (University of California, San Diego School of Medicine); Pavel Afanasyev (MRC Laboratory of Molecular Biology, Cambridge, U.K.); Paula C.A. da Fonseca (MRC Laboratory of Molecular Biology); Elizabeth A. Winzeler (UCSD); and Caroline L. Ng (CUIMC and University of Nebraska Medical Center).
The research was supported by the U.S. National Institutes of Health (grants R33AI127581, R01AI109023, R01AI124678, R21AI137900, T32AI106711, T32GM008666) and the U.K. Medical Research Council (grant MC_UP_1201/5).